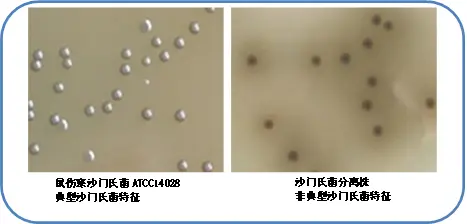
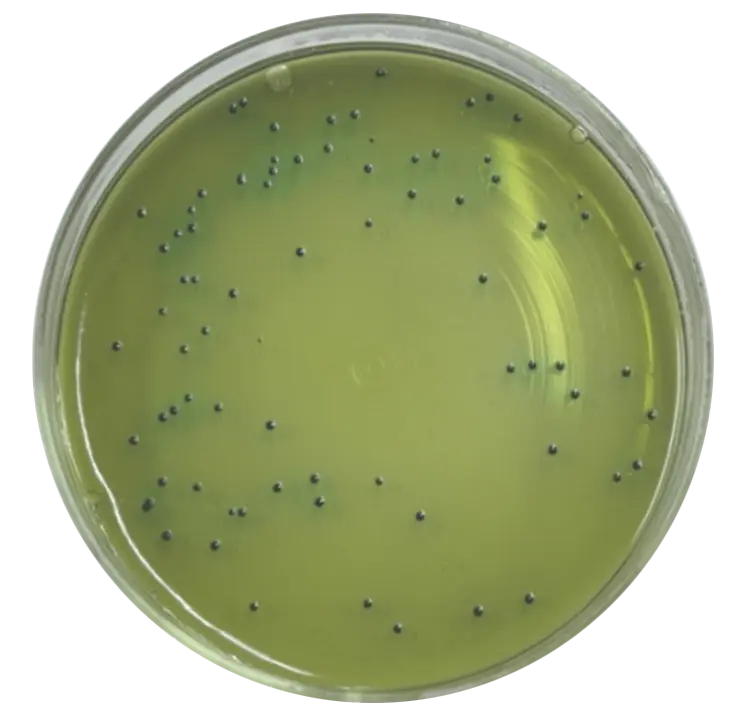
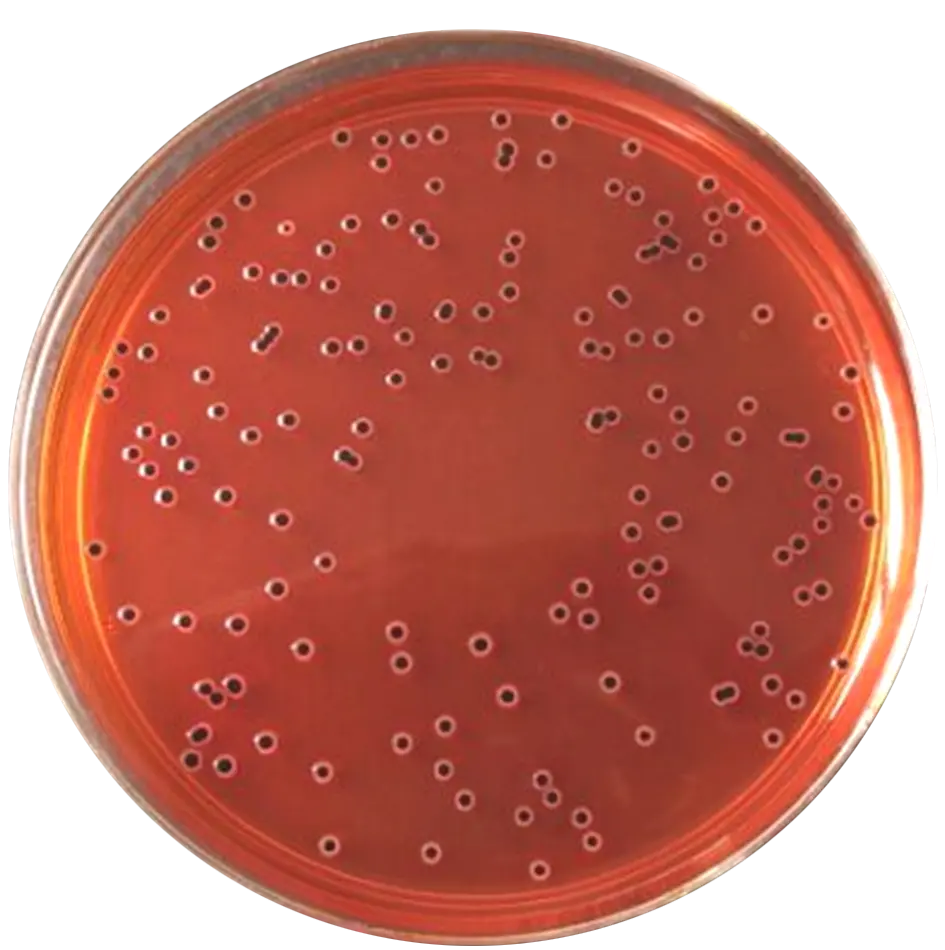
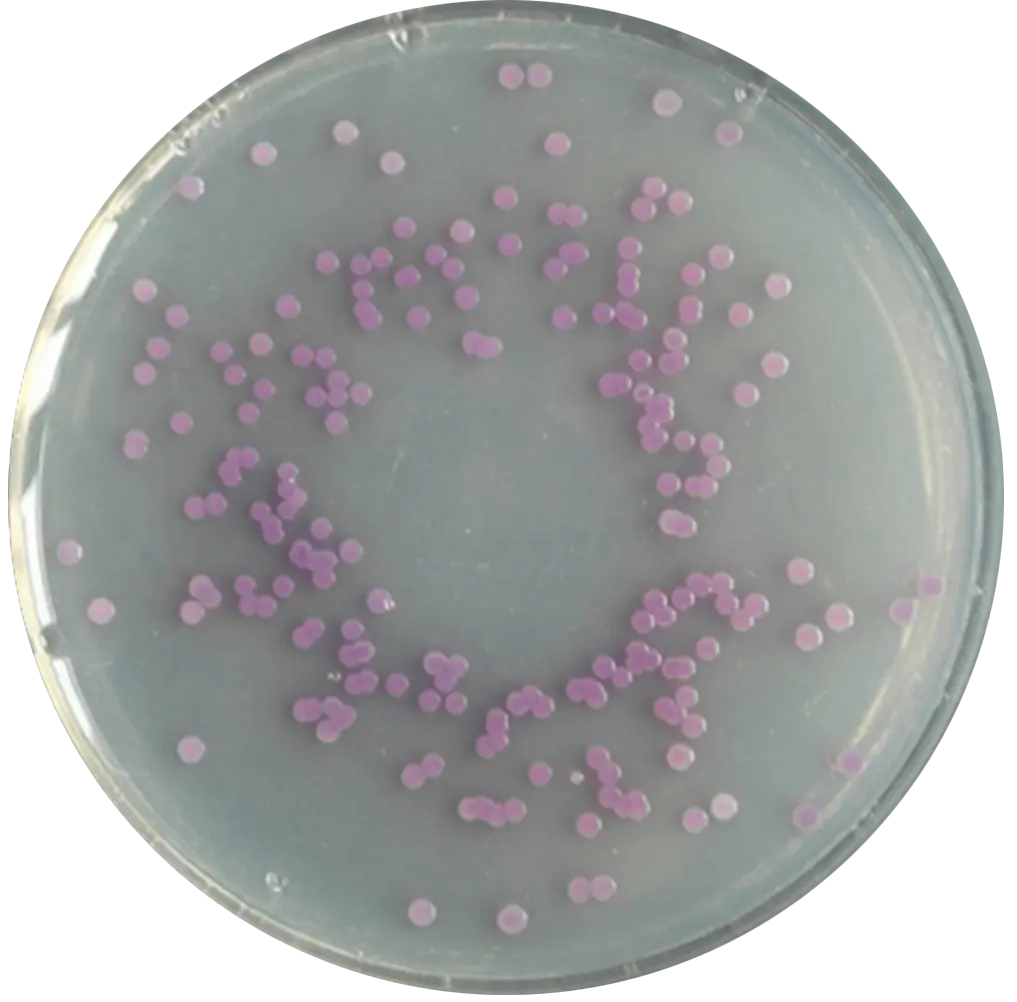

食品微生物检验沙门氏菌检验常用培养基原理解析
发布时间:2020-09-21 浏览次数:16381
沙门氏菌检验常用培养基如缓冲蛋白胨水、四硫磺酸钠煌绿增菌液(TTB)、亚硫酸铋琼脂培养基、HE琼脂培养基及赖氨酸脱羧酶试验、靛基质试验等原理解析。
•配方中硫代硫酸钠和碘经氧化生成四硫磺酸钠,它对大肠菌群有抑制作用,对沙门氏菌无影响(因沙门氏菌具有四硫磺酸酶,能分解四硫磺酸钠,而大肠菌群没有这种酶,故生长受抑制);
•碳酸钙为缓冲剂,可使沙门氏菌不致因酸碱度改变面死亡。
•由于配方含碳酸钙,因此,该培养基配置后的最终pH不在7.0±0.2,而是偏碱性。

四硫磺酸钠煌绿增菌液(TTB)
2. 缓冲蛋白胨水(BPW)
•其成分中含有磷酸二氢钾和磷酸氢二钠,起缓冲液的作用;
•蛋白胨提供生长营养,有利于损伤沙门氏菌的复苏。
•配方中亚硫酸钠可与柠檬酸铋铵生成亚硫酸铋,抑制革兰氏阳性菌和大肠菌群;硫酸亚铁可产生硫化氢,并与铁反应生成黑色沉淀。
•沙门氏菌在BS上的典型菌落特征:具有金属光泽的棕色或黑色菌落。但有些菌株形成非典型菌落特征:灰绿色的菌落,周围培养基不变。
•BS平板应制备后避光常温保存,并在24h内使用。
亚硫酸铋琼脂(BS)菌落特征
4. 亚硒酸盐胱氨酸增菌液(SC)
•蛋白胨提供碳源和氮源满足细菌生长的需求;乳糖是可发酵的糖类;亚硒酸氢钠抑制革兰氏阳性菌和非沙门氏菌的大多数革兰氏阴性肠道菌;磷酸盐是缓冲剂;L-胱氨酸为还原剂。
•使用过程中要注意SC培养基不稳定,配置时避免过度加热。

亚硒酸盐胱氨酸增菌液(SC)
5. HE琼脂培养基
•HE琼脂培养基配方中胆盐、去氧胆酸钠、溴麝香草酚兰等成分可抑制革兰氏阳性菌生长;酸性复红作为酸碱指示剂的同时,也可抑制阳性菌,但对阴性肠道菌无抑制作用,选择性较弱。硫代硫酸钠可被细菌还原产生硫化氢,与柠檬酸铁铵反应生成黑色硫化亚铁。
•菌落特征:蓝绿色或蓝色,多数菌落中心黑色或全几乎全黑色;有些菌株为黄色,中心黑色或几乎全黑色。
HE琼脂菌落特征——鼠伤寒沙门氏菌ATCC14028
6. XLD琼脂培养基
•XLD琼脂培养基配方中木糖、乳糖和蔗糖成分作为可发酵的碳源,除志贺氏菌外,其他大多数肠杆菌均能发酵木糖;沙门氏菌发酵木糖产酸,形成酸性环境有利于产生脱羧酶使赖氨酸脱羧,从而使培养基的pH值升高向碱性转变;在碱性条件下,硫代硫酸钠及柠 檬酸铁铵成分与沙门氏菌产生的硫化氢反应是的菌落的颜色呈黑色;去氧胆酸盐成分可抑制革兰氏阳性菌的生长。
•菌落特征:菌落呈粉红色,带或不带黑色中心,有些菌株可呈现大的带光泽的黑色中心,或呈现全部黑色的菌落;有些菌株为黄色菌落,带或不带黑色中心。如下图所示:
XLD琼脂菌落特征——鼠伤寒沙门氏菌ATCC14028
7. 沙门氏菌显色培养基
•蛋白胨和酵母膏粉提供碳氮源和微量元素;氯化钠可维持均衡的渗透压;琼脂是培养基的凝固剂;胆盐抑制革兰氏阳性菌;选择性添加剂增强培养基的抑制杂菌的能力;混合色素分别与沙门氏菌和大肠菌群所对应的酶发生特异性反应,水解底物,释放出显色基团,在淡黄色平板上沙门氏菌产生品红色的菌落,大肠菌群产生蓝绿色的菌落。如下图所示:
CRM004 沙门显色培养基——鼠伤寒沙门氏菌ATCC14028
8. 三糖铁琼脂培养基
•蛋白胨、牛肉膏粉提供氮源、维生素、矿物质;乳糖、葡萄糖、蔗糖为可发酵糖类,其产酸时通过酚红指示剂测出,酸性呈黄色,碱性呈红色;硫代硫酸钠可被某些细菌还原为硫化氢,与硫酸亚铁铵中的铁盐生成黑色硫化铁;氯化钠维持均衡的渗透压;琼脂是培养基的凝固剂。

三铁塘
9. 赖氨酸脱羧酶试验培养基
•具有氨基酸脱羧酶的细菌,能分解氨基酸使其脱羧生成胺(赖氨酸→尸胺)和二氧化碳,使培养基变碱,使指示剂显示出来。
•结果判读:阳性为试验管为绿色-蓝绿色,对照管变黄色; 阴性为试验管和对照管均变黄色,或均不变色。

赖氨酸脱羧酶试验阳性
10. 靛基质试验(靛基质试剂)
•某些细菌能分解蛋白胨中的色氨酸,生成吲哚。吲哚的存在可用显色反应表现出来。吲哚与对二甲基氨基苯醛结合,形成玫瑰吲哚,为红色化合物。
•结果判读:阳性为滴加靛基质试剂后液面立即变玫红色;阴性为滴加试剂后不变红色。

靛基质试验
11. 尿素酶试验
•具有尿素酶的细菌分解培养基中的尿素,产生大量的氨,使培养呈碱性,酚红指示剂在pH6.8时呈黄色,pH8.1呈粉红色。
•结果判读:阳性为玫红色; 阴性为淡橙红色-淡黄色。

尿素酶试验
12. 氰化钾利用试验
•氰化钾是细菌呼吸酶系统的抑制剂,可与呼吸酶作用使酶失去活性,抑制细菌的生长,但有的细菌在一定浓度的氰化钾存在时仍能生长,以此鉴别细菌.。
•结果判读:阳性为试验管和对照管都有生长变浑浊; 阴性为试验管澄清不见生长,对照管生长浑浊。

氰化钾利用阴性结果
13. 糖(醇)发酵试验
•绝大多数细菌都能利用糖(醇)类作为碳源和能源,但是它们在分解糖(醇)的能力上有很大的差异,有些细菌能分解某种糖(醇)并产酸(如乳酸、醋酸、丙酸等)和气体(如氢、甲烷、二氧化碳等);有些细菌只产酸不产气。酸的产生可利用指示剂来断定。
•(指示剂为溴甲酚紫)结果判读:阳性为变黄色;阴性为紫色。

甘露醇发酵试验
